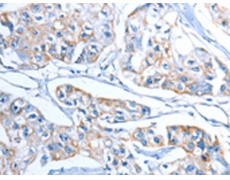
一抗

中文名稱: 兔抗ADSL多克隆抗體
|
Background: |
Adenylsuccinate lyase is involved in both de novo synthesis of purines and formation of adenosine monophosphate from inosine monophosphate. It catalyzes two reactions in AMP biosynthesis: the removal of a fumarate from succinylaminoimidazole carboxamide (SAICA) ribotide to give aminoimidazole carboxamide ribotide (AICA) and removal of fumarate from adenylosuccinate to give AMP. Adenylosuccinase deficiency results in succinylpurinemic autism, psychomotor retardation, and , in some cases, growth retardation associated with muscle wasting and epilepsy. Two transcript variants encoding different isoforms have been found for this gene. |
|
Applications: |
ELISA, IHC |
|
Name of antibody: |
ADSL |
|
Immunogen: |
Fusion protein of human ADSL |
|
Full name: |
adenylosuccinate lyase |
|
Synonyms: |
ASL; AMPS; ASASE |
|
SwissProt: |
P30566 |
|
ELISA Recommended dilution: |
1000-2000 |
|
IHC positive control: |
Human breast cancer and Human lung cancer |
|
IHC Recommend dilution: |
15-50 |

 購物車
購物車 幫助
幫助
 021-54845833/15800441009
021-54845833/15800441009